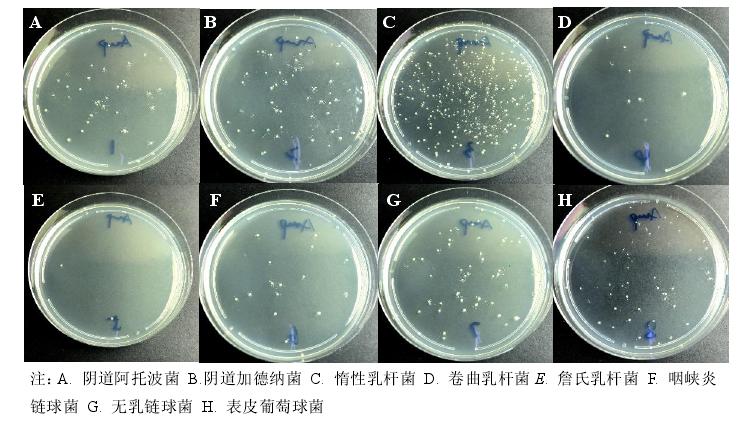
给女票搓了一年内衣，我想明白一个事儿——专用洗衣液微横测

一、前言
算下来我已经给女票洗了快一年的胖次了。
书中自有颜如玉,不仅仅书里有,书外头也有。
说起来我还是觉得很神奇的,特别是女孩子的胖次(其实被胖次包住那部分更神奇),要洗,要细细地洗……
那么到底是什么让胖次如此重要呢?
生理原因
在洗之前习惯性地会闻一闻,发现这味道确实不一样,不一样……
这个味道怎么形容呢?
酸酸的
这是为什么呢?
有事不决问百度,再不靠谱翻知网啊!(还记得翟博士不?他就不知道这玩意)
关于微生物这事,今年看过的《我包罗万象》就已经讲得很透了,正常人体内的微生物种群主要分布在体表、口腔、呼吸道、胃肠道和生殖道。
《我包罗万象》是一本关于微生物的科普书,透过微生物可以认识到生命场景的另一面。大体是说不同部位的微生物群落由有特定种群组成,并具有自己的优势菌群。这些微生物群在人体中发挥着重要作用,密切影响人体的人的生理、免疫、抗肿瘤、药物效能等密切相关,微生物菌群、宿主和环境构成了一个相互依存、相互依赖的生态系统。有兴趣可以买这本书详细了解一下
又说回女朋友的胖次——(认真脸)维持女性阴道微环境中微生物之间的生态平衡构成了抵抗病原体的第一道防线。阴道微生态为阴道内正常的定植菌群、宫颈阴道解剖结构、宿主免疫功能及体内外环境之间构成一个重要的微生态系统。正常情况下这个菌群由厚壁菌门组成,主要包括革兰阳性需氧菌和兼性厌氧菌、革兰阴性需氧菌、兼性厌氧菌、专性厌氧菌和支原体及念珠菌。
在这个系统中乳酸杆菌属占绝对优势,还有其他丰度较低的加德纳菌属、普雷沃菌属及奇异菌属等。作为重要的生物屏障,阴道菌群这些菌群抵抗外来病原菌侵袭,它还在维持阴道的酸性环境(→_→难怪闻起来发酸)和激活免疫功能方面发挥重要作用。
正如《我包罗万象》中所说的
寄生于阴道中的微生物可以与宿主发生一系列复杂的相互作用,显著影响阴道的生理机能和免疫功能,并在抵御机会性病原体的定植过程中发挥“第一道防线”作用。
在正常情况下,女性阴道微生态处于平衡状态,当非优势菌群或病原体繁殖时,优势菌群不再为乳酸杆菌,动态平衡被打破,容易被外来微生物侵袭,引起细菌性阴道炎、滴虫性阴道炎、念珠菌性阴道炎、混合感染性阴道炎和其他下生殖道感染性疾病。

我们常见的酵母菌,大量存在于空气中,如果这东西进入阴道,依然会造成发炎。
既然是菌种环境了,那我这书没白看。
首先,就是去污渍,胖次得干净着才能穿不是!
其次,不能影响微环境,这就要求洗涤剂最好是中性的,降低对环境的干扰。
再就是洗涤剂是不能有荧光剂,这是常识了,这玩意真的有毒!
最后,不能有“杂菌”污染,这就要求胖次最好在洗的时候有灭菌的功能。
在这一年的时间里,一直以来我都是用内衣皂来洗的(事实上是因为女票的要求),手本来就糙,倒也无所谓伤手与否……
不过重要的女朋友重要的胖次,就不能敷衍了。正好有机会比较一下不同的洗涤剂的效果和作用。
家里原本有内衣皂和洗衣液了,然后又买了据说很厉害的网红小林,常见的威露士,以及女朋友闺蜜推荐下新入手的安洁。

对比项目1、去血渍的效果2、是pH值3、荧光剂4、除菌方式
普通家用洗衣液的泡沫与清洗——参照组
家里洗衣液是卫新的,显然不能拿来洗胖次,在这里只是对照组。洗完有明显污渍,难漂洗干净的,洗完浓郁香气让人不太舒服,晾干手感绵软。
洗衣皂就不用说了,虽说省却了浸泡过程,但需要更大的力气搓洗,而且洗衣皂作为皂基的洗涤剂,需要更长时间的漂洗。
其实洗衣皂在这里可以作为参考,显然,这肥皂以后我是不大想再继续用下去了。
二、去血渍&去污
发黑是女票的意见,胖次最难洗的不是鲜红的新鲜血渍,而是那些放得有点久的血渍。用了血渍剂,放了3天发黑后进行测试。胖次的材质是纯棉。
首先是小林

搓洗之后
一分钱一分货,不愧是网红小林!
这是四种里面去污效果最好的,效果虽好但是却并不容易漂,在刚刚开始浸泡胖次的时候一点泡沫都不起,但是搓洗之后泡沫却非常难漂。
最诡异的是小林洗完之后胖次的手感变了,棉质发硬,手感干涩,洗完有淡淡的香味。

安洁刚加进去就起泡了,浸泡20分钟后,进行搓洗。
洗完以后胖次恢复原本的颜色,血渍没有了,有泡沫不算绵密。安洁漂洗很容易的,泡沫不多,但是几下就冲干净了。
这款的晾干后的味道应该是三款最好的,但又说不清楚是什么香味,瓶上说这叫“伊甸园香型”,闻着很舒服,晾干之后基本没什么味道。
晾干之后胖次的手感也不错,柔软而顺滑。

没拍出来效果,肉眼看有些微微泛黄,不像小林的亮白和安洁的恢复原色
威露士刚开始浸泡胖次的时候就已经有了泡沫漂浮在表面,搓洗之后泡沫多而且绵密,非常丰富。
意外的是虽然泡沫多,但是却比较容易漂。威露士是没有香味的,洗完之后晾干的胖次还是挺绵软的。
其实三种洗液的设计还是很讨巧的,小林倒置瓶子挤出一格(10mL),而威露士和安洁都是按压式的我更喜欢,泵的使用非常方便定量,也不易溢出。
洗涤效果的主要因素其实就是表面活性剂,高中学理的都知道这玩意其实是怎么回事,只要一个分子结构一端是亲水基,另一端亲油基,这个时候接触污渍的时候,亲油基与之结合,亲水基与漂洗的水结合,在这个过程中表面活性剂就像一根绳子,水就直接把污渍拽了下来。
而胖次之所以难洗,其实还是每月难题——血渍,血渍为血红蛋白,清除蛋白可以用的自然只能是蛋白酶了,而这显然是这三款都有但效果稍有差异。

三、pH值
pH的测定自然是直接用pH试纸啦!便宜!好用!

家用洗衣液简直太巨大了,pH值=7,中性的

小林这个吓了我一大跳……
pH值=10
这是要干啥啊?!

安洁的pH值=8,接近中性可以接受

威露士的pH值=7
我终于知道为嘛小林洗完之后胖次的手感变差了!这么强的碱性再加上浸泡,损伤布料是必然的。
从pH值来看,威露士是中性的,安洁接近中性,影响不大,反而小林的碱性则有些太强了。这么强的碱性对手以及对织物都是一种巨大的伤害。
四、荧光剂
荧光剂的危害就不用说了,残留之后发生蓄积,进而危害肝脏和血液,据说还有潜在的致癌危害。
荧光剂也比较好测,涂抹之后在暗处用荧光笔照射,呈现蓝色的则是有荧光剂,呈现原色的则没有。
我涂抹在餐巾纸上了。

本着严谨的态度,先上参照组——餐巾纸照射不发蓝,没有荧光剂

洗衣液里没有

有点知道小林为什么洗完之后有一种闪亮的洁净感了,这玩意有荧光剂啊~

安洁里没有

威露士里也没有
在挤压这个环节还发现了一些不一样的地方,威露士是最粘稠的,涂抹在餐巾纸上的时候也比较麻烦。而安洁是最好涂抹的,非常轻松地就在餐巾纸上涂抹开。
好了,小林有荧光剂,难怪洗完之后有一种闪亮亮的感觉,真的可以首先把小林pass掉了,荧光剂+强碱性。都是用泵压出,安洁更好挤压和涂抹,均匀地覆盖在胖次上,也好溶解。
五、灭菌
胖次是给女生最贴身的保护,回到开头说的就是保护阴道的微生物菌群的平衡不被打破。除了以上说的洗的干净、pH值、没有荧光剂等等,还有一项最重要的就是灭菌,防止胖次贴身导致杂菌滋生,进而破坏体内菌群平衡。
对一个优质的消毒剂而言,第一点是它的本职:消毒能力强、杀死病原微生物、作用迅速,其次是它对环境的贡献:无毒、无残留、无腐蚀、无刺激……更重要的,必须对人和动物无害,对环境污染程度小。
我们常见的灭菌剂也有很多:氧化类、醛类、酚类、醇类、碱盐类、卤素类和表面活性剂类。
氧化类:其杀菌机理是释放出新生态原子氧,氧化菌体中的活性基团;杀菌特点是作用快而强,能杀死所有微生物,包括细菌芽孢、病毒。它主要用于表面消毒,该类消毒剂为灭菌剂。
醛类:杀菌机理是使蛋白变性或烷基化;杀菌特点是对细菌、芽孢、真菌、病毒均有效,但是温度对其效果影响较大。该类消毒剂可做灭菌剂使用。
酚类:杀菌机理是使蛋白变性、沉淀或使酶系统失活;杀菌特点是对真菌和部分病毒有效。
醇类:杀菌机理是使蛋白变性,干扰代谢;杀菌特点是对细菌有效,对芽孢、真菌、病毒无效。该类消毒剂为中效消毒剂,只能用于一般性消毒。
碱盐类:杀菌机理是使蛋白变性、沉淀或溶解;杀菌特点是能杀死细菌繁殖体、细菌芽孢、病毒和一些难杀死的微生物。杀菌作用强,有强腐蚀性。
卤素类:杀菌机理是氧化菌体中的活性基因,与氨基结合使蛋白变性;特点是能杀死大部分微生物。
卤素类消毒剂以表面消毒为主,性质不稳定,杀菌效果受环境条件影响大。
表面活性剂类:杀菌机理是改变细胞膜透性,使细胞质外漏,妨碍呼吸或使蛋白变性;杀菌特点是能杀死细菌繁殖体,但对芽孢、真菌、病毒、结核病菌作用差。
而落到洗衣液这个层面上,要注意的一点是,表面活性剂一方面是清洗剂,另一方面也是一种灭菌剂,所以在成分的视角看起来,表面活性剂≈灭菌剂这个约等号是成立的。
但是为什么还需要特意写出灭菌呢?按照这个说法岂不是一般的洗衣液也能洗胖次了?
显然,这个说法对也不对,表面活性剂多了去了,但是能灭菌,还是要额外加点东西的。
我们常见的灭菌剂一般是三类:卤素类、酚类和表面活性剂类。
卤素类——很容易理解,84消毒液,次氯酸钠的水溶液,从小用的太多了。一般能消灭肠道致病菌、化脓性球菌和细菌芽孢,这玩意味道多数人都闻过,伤手伤色大家都知道,显然不能洗胖次。
酚类——比如英国皇家滴露、威露士,它通过使蛋白质变性来达到杀菌效果,味道相对84好闻,但是浓度掌握不好味道也很上头,而且容易残留。对氯间二甲基苯酚对多数革兰氏阳性菌、阴性菌、真菌、霉菌都有杀灭功效。
表面活性剂——比较常见的是单双链复合季铵盐。比如安洁,前身是帮伊利、蒙牛等食品企业做供应链消毒的。单双链复合季铵盐能改变菌体细胞膜通透性,酶、辅酶和中间代谢物逸出,从而导致菌体蛋白酶变性。对细菌繁殖体、金黄色葡萄、大肠杆菌、球菌、真菌和病毒都有杀菌作用。
不同的灭菌剂针对不同的菌。用含1000mg/L对氯间二甲基苯酚消毒液对白色念珠菌分别作业 3min和5min,平均杀灭对数值分别为3.91和4.62。而季铵盐对金黄色葡萄球菌作用3min,杀灭率为99.99%;对大肠杆菌作用5min,杀灭率可达到100%。
综上
显然不能用84洗胖次,毕竟这玩意的腐蚀性和刺激性超级强;
对氯间二甲基苯酚消毒液的残留和毒性都很大;
复合季铵盐则是一种无腐蚀、低刺激、低毒,安全性较强的杀菌剂,更重要的是复合季铵盐对生物的增殖与生长也无影响,还不会产生抗药性,也不会在产生残留。同时,它比一般阳离子表面活性剂的杀菌能力更高。
贴身衣物的除菌还是建议使用复合季铵盐类的,高效的同时更安全不残留。
说了这么多,再来看看这三款洗衣液的成分表。
小林虽是其中最伤布料的洗衣液,但也坦诚地写了3种表面活性剂(仲烷基磺酸钠、聚乙烯烷基醚、烷基硫酸钠)+安定化剂。
威露士则是非常“废话”地写了:多种表面活性剂+抗再沉淀剂+杀菌剂(威露士主打活性氧杀菌,我很好奇这是用什么来氧化的,这些成分你写在这里是用来充位置的么?)。
安洁也不够详细:超强去渍因子+护色柔顺因子+活性助洗因子+季安康+生物酶。这里最生疏的就是这个季安康,是安洁和军工实验室合作的专利杀菌技术:这玩意就是季铵盐氢氧化物内盐,CSA:100085-64-1,一种稳定的消毒剂,在我看来,其实并不难理解,也就是经过加工处理的复合季铵盐,杀菌和安全性有一定的提升。
除了灭菌剂之外的成分,去污渍效果,漂洗效果,以及洗了之后的手感,这都是洗一下直接就能感受到的,最难以直观感受的就是这个灭菌效果(那怕我确实会用显微镜,但我没必要买一台吧,这玩意其实挺贵的)。

六、总结
首先要承认的是小林洗得是真的干净,只是荧光剂+强碱性双杀之后,我是真的不大敢用了。
安洁与威露士两款性价比都不错,我选安洁,主要是去污效果、漂洗方便和洗后的手感以及味道让我觉得安洁更好一点,相对安全的杀菌成分也更安心。不过,对于内衣洗衣液而言,希望各家能把成分写的更清楚一些,让我能更放心的给女朋友洗胖次。